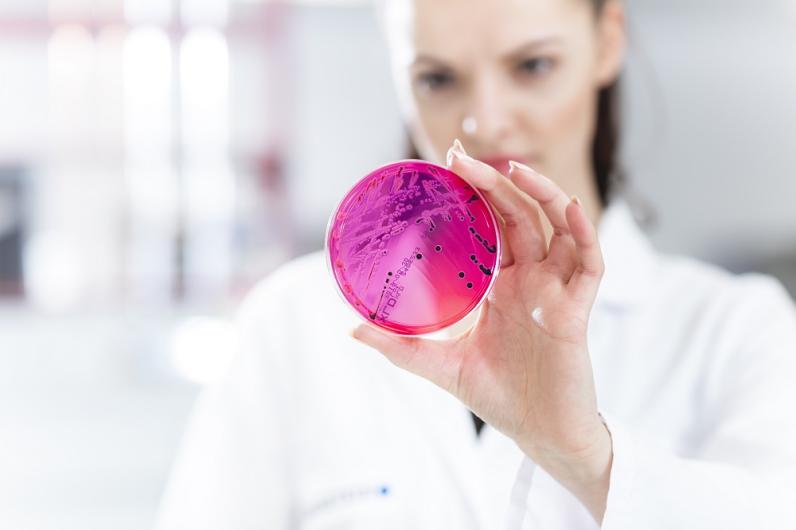

The exhibitors & products at Techtextil 2026 will be available here from mid-January 2026.
Health
Health
Description
We are your experts for textiles in the fields of life science and medicine.
Whether you need protection from harmful UV radiation, an exclusion of allergy potential, tests for harmful substances or skin compatibility - the demands on textiles and leather products now extend far beyond fit, style and trend. Consumers always want to be sure that their health and that of their loved ones is not negatively affected in any way. But this field goes even further. From the antimicrobial finish for textiles and surfaces to microbiological and mechanical requirements of medical products to the effectiveness of textiles that are used in healthcare or for treatments - approaches and requirements are varied.
With our tests and certifications we want to make sure that hygienic requirements in medicine are observed just as they are in companies, industrial laundries and in the home. Benefit from us as an independent test laboratory for both textiles and in the medical sector so that you can give your customers the reassurance that your products are trustworthy. Because ultimately, the trust of your customers in your products and in your company is worth its weight in gold.
Our services for you: Medical Compression Textiles, Applied Hygiene, Medical Products, Medical Face Masks, Harmful Substances, UV Protection.




